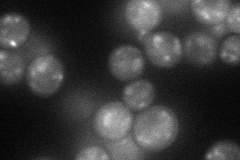
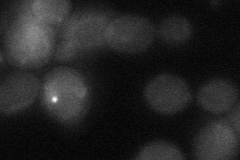
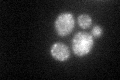
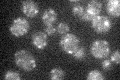

View description
Subunit of a Golgi membrane exchange factor (Ric1p-Rgp1p) that catalyzes nucleotide exchange on Ypt6p
Localization:
Intensity:
Fold change:
Significance:
-
C’ GFP library in SD

punctate23.15 -
N' NOP1pr-GFP in SD
punctate66.8158 -
N' TEF2pr-mCherry in SD

punctate61.8493 -
N' NATIVEpr-GFP in SD

punctate26.0197 -
N' TEF2pr-VC and Cyto-VN in SD
below threshold27.1383 -
C’ GFP library in SD+DTT
punctate24.41.05No -
C’ GFP library in SD+H2O2

punctate25.261.09No -
C’ GFP library in Starvation Media
punctate20.430.88No -
C’ GFP library on the background of Pup2-DaMP

punctate -
C’ GFP library on the background of CCT mutant

punctate24.60831.06256No
